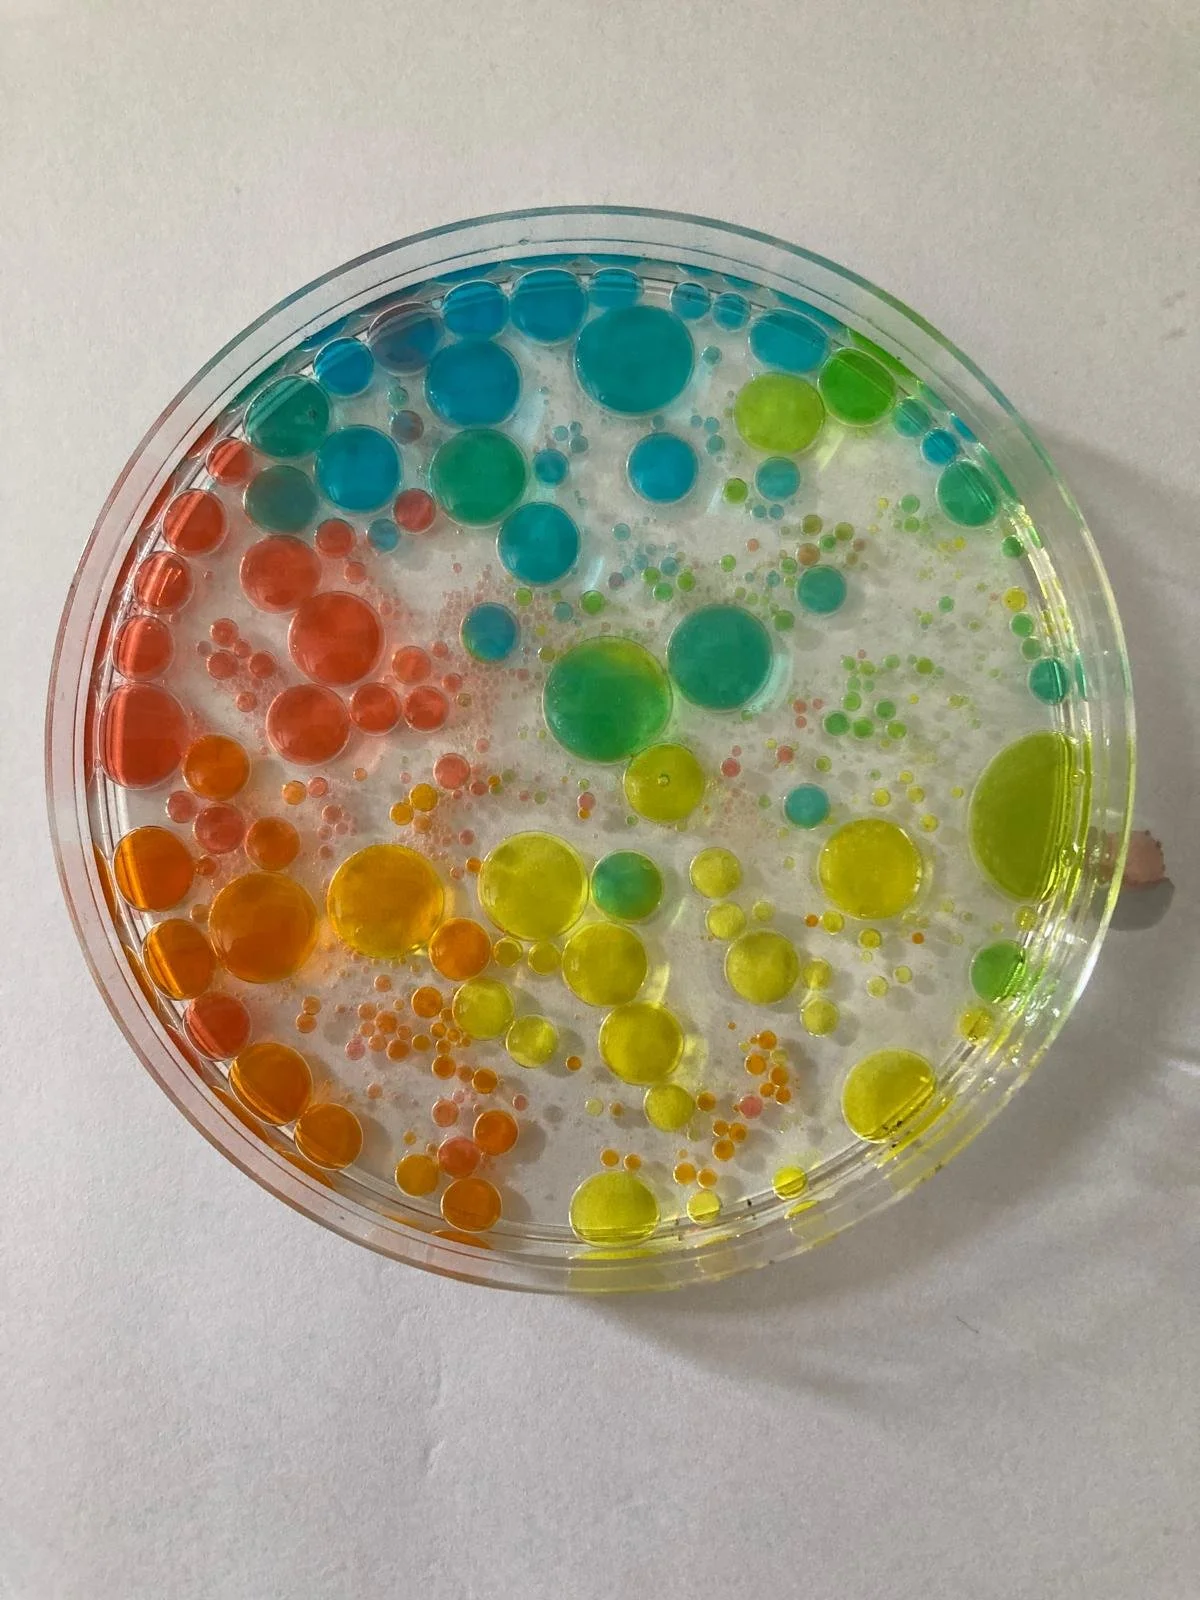
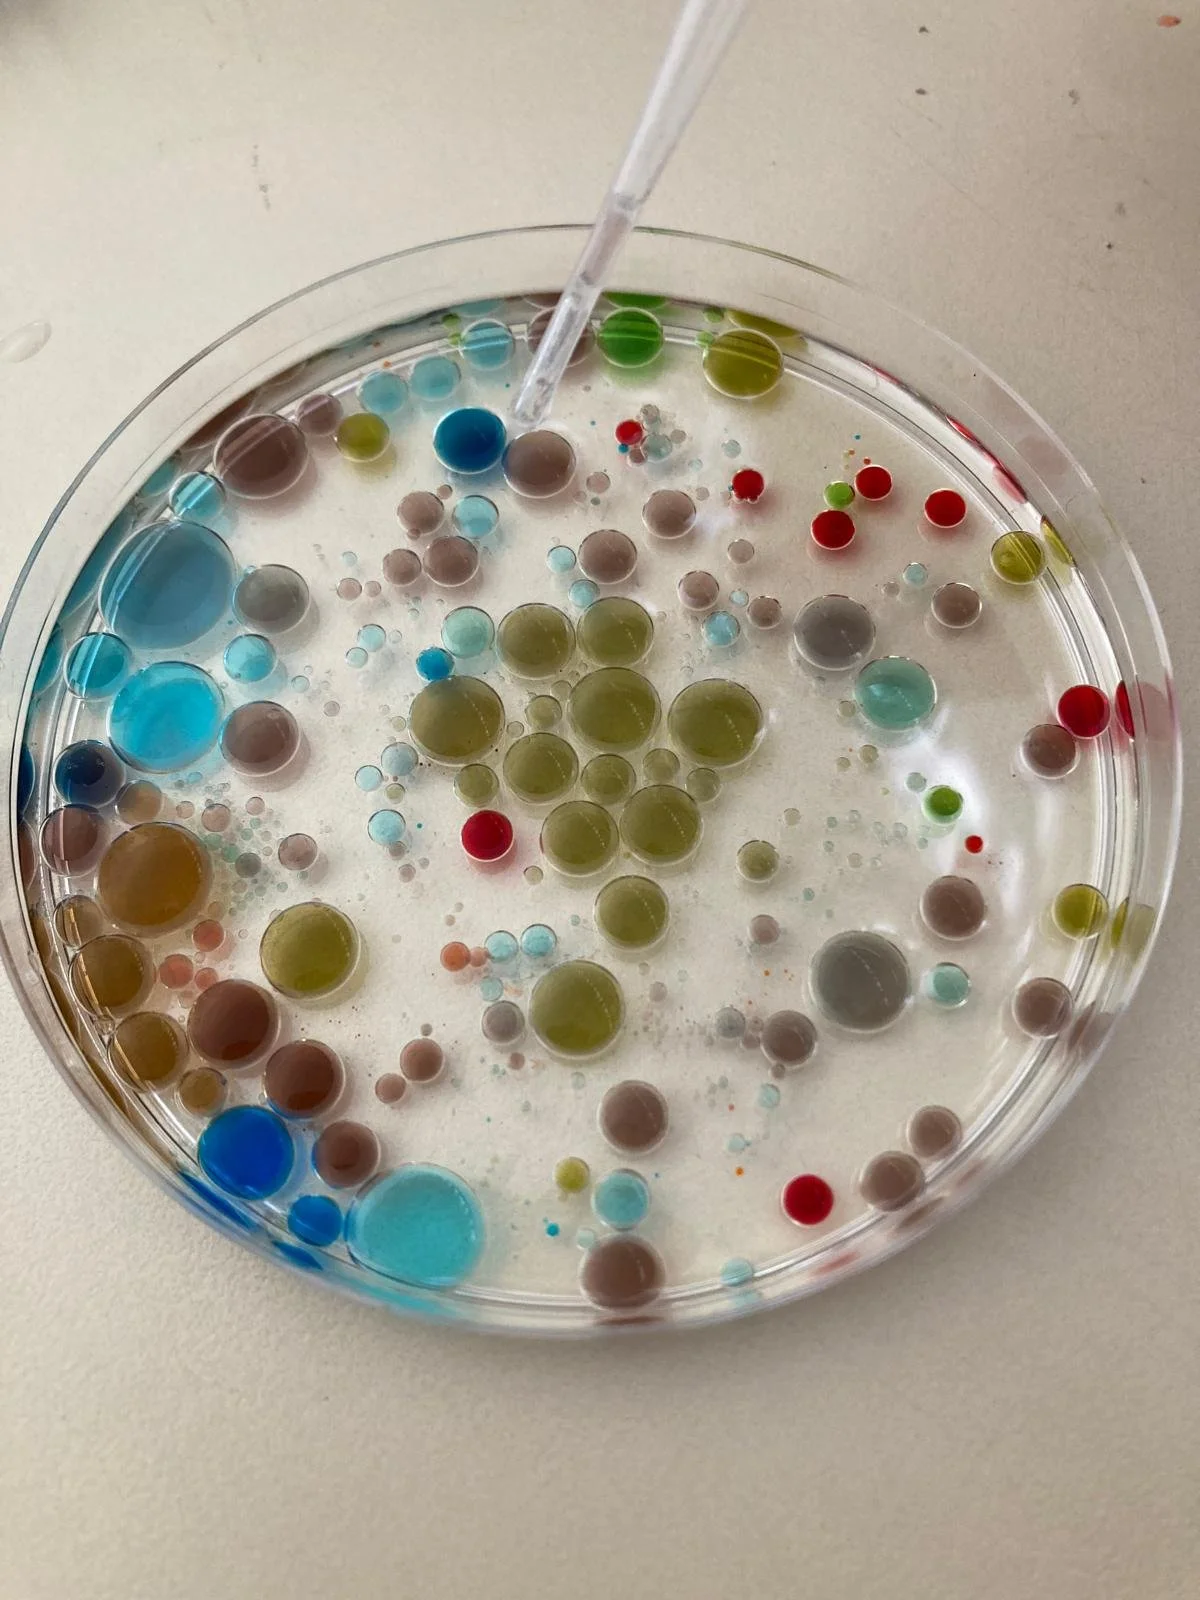

Playa Vida Learning is currently closed.
The center opened in September 2025 and is not operating at this time due to a medical situation involving our director. We will share updates here as future plans become clearer.

PLAYA VIDA LEARNING
Playa Vida Learning was founded in Playa El Zonte as a full-curriculum, bilingual education hub rooted in academic excellence, real-world skills, and community involvement. Our vision centers on holistic, community-based education that prepares children not only academically, but for life.
Education for a New Generation
Our bilingual curriculum balances freedom with structure, blending guided lessons and self‑directed projects so that learning feels alive, practical, and connected to community and nature.
Inspired by Waldorf principles and co‑created with families and mentors, we integrate academics with creativity, emotional intelligence, and real‑world responsibility.
Core focuses:
Bilingual Language Arts — English and Spanish
Social–Emotional Learning
Nature & Practical Life
Creative Arts & Movement
Modern Literacies — technology, finance, and health
Mission Statement
To provide a nurturing learning environment that balances freedom and structure. Through creative and project-based learning, time in nature, meaningful academics, and community skill-sharing, students explore and thrive. Staff, parents, and teachers guide a diverse educational experience that helps learners grow into confident, healthy, respectful, and sovereign individuals with a strong sense of purpose in the greater community.

Get in Touch
For updates about future developments or opportunities, please contact us.